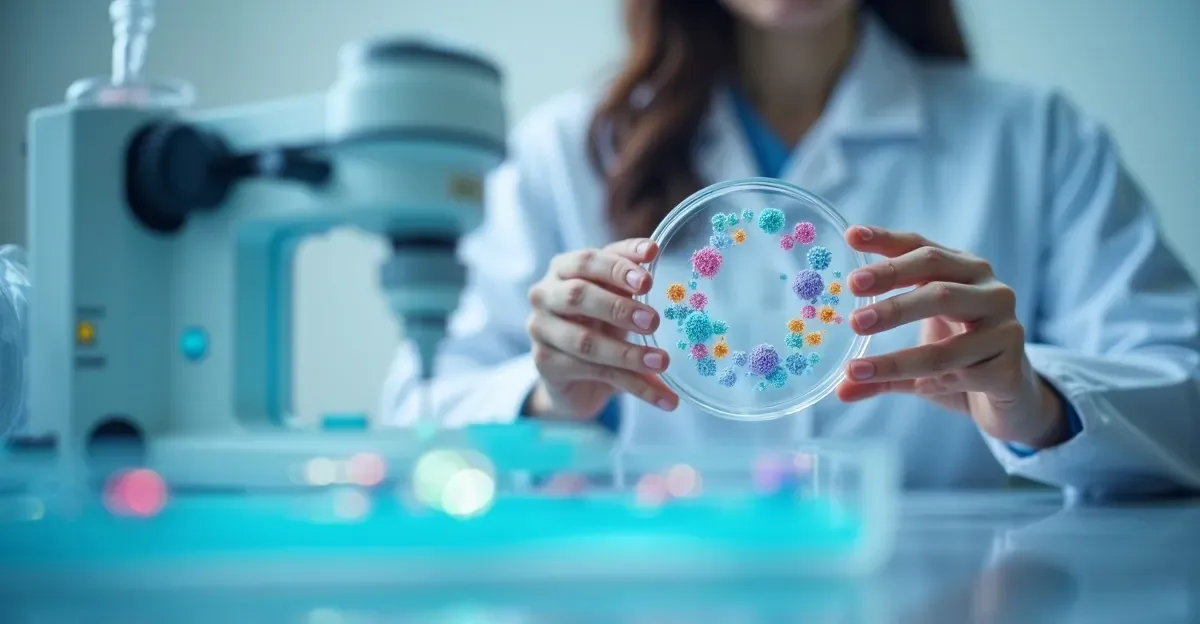
Terapia celowana: Co musisz wiedzieć o leczeniu nowotworów

Terapia celowana molekularnie to nowoczesne podejście do leczenia nowotworów, które skutecznie zwalcza chorobę, jednocześnie ograniczając nieprzyjemne skutki uboczne. Co sprawia, że jest tak skuteczna? Klucz tkwi w tym, że koncentruje się na genetycznych właściwościach nowotworów. Jak to działa w praktyce? Dzięki testom genetycznym możliwe jest dostosowanie terapii do konkretnego pacjenta, co oznacza, że każdy otrzymuje leczenie idealnie dopasowane do swoich unikalnych potrzeb.
Zalety tej metody są naprawdę imponujące:
- ryzyko wystąpienia skutków ubocznych jest znacznie mniejsze,
- możliwość dostosowania terapii do indywidualnych potrzeb pacjenta,
- potencjał do zwiększenia skuteczności leczenia nowotworów w przyszłości.
Co to jest terapia celowana molekularnie w onkologii?
Terapia celowana molekularnie w onkologii to nowatorska metoda, która skupia się na specyficznych cechach genetycznych nowotworów. W odróżnieniu od tradycyjnej chemioterapii, która atakuje wszystkie szybko dzielące się komórki, ta terapia precyzyjnie identyfikuje i uderza w słabe punkty komórek rakowych. Taki sposób leczenia minimalizuje uszkodzenia zdrowych tkanek, co przekłada się na mniejsze ryzyko skutków ubocznych i wyższą efektywność.
Terapia celowana przybiera różne formy, w tym:
- terapie biologiczne,
- immunoterapie,
- indywidualne podejście do pacjentów.
W polskiej onkologii zauważalny jest wzrost znaczenia tego podejścia. Coraz więcej osób korzysta z zindywidualizowanego leczenia, które uznawane jest za przełom w onkologii personalizowanej. Dzięki zrozumieniu genetyki nowotworów lekarze są w stanie lepiej przewidzieć skuteczność terapii i dostosować leczenie do konkretnych mutacji genetycznych, co znacząco zwiększa szanse na pozytywne wyniki.
Jakie są korzyści z terapii celowanej?
Terapia celowana przynosi szereg korzyści, które znacząco wpływają na skuteczność leczenia pacjentów z nowotworami. Oto kilka kluczowych zalet:
- znacznie mniejsza ilość skutków ubocznych w porównaniu do tradycyjnej chemioterapii,
- możliwość personalizacji terapii dostosowanej do unikalnych potrzeb pacjenta,
- wybór najbardziej efektywnej strategii terapeutycznej z uwzględnieniem genetycznych właściwości nowotworu,
- szybsze rezultaty, co podnosi komfort życia pacjentów,
- możliwość stosowania w połączeniu z innymi metodami leczenia, co zwiększa efektywność.
Taki spersonalizowany plan zwiększa szanse na pomyślne wyniki. Na przykład, inhibitory kinaz mogą w krótkim czasie znacznie zmniejszyć rozmiar guza. Dodatkowo, zintegrowane podejście do leczenia zapewnia pacjentom bardziej kompleksowe wsparcie w walce z chorobą, co przekłada się na lepszą jakość życia na dłuższy czas.
W jaki sposób terapia celowana zmienia leczenie nowotworów?
Terapia celowana przekształca podejście do leczenia nowotworów, wprowadzając bardziej zindywidualizowane metody, które często okazują się efektywniejsze niż tradycyjna chemioterapia. Dzięki precyzyjnemu skupieniu się na unikalnych cechach komórek rakowych, ta forma leczenia minimalizuje uszkodzenia zdrowych tkanek, co prowadzi do mniejszej liczby skutków ubocznych dla pacjentów. Na przykład, w przypadku zaawansowanego raka płuc, wiele osób korzysta z terapii celowanych oraz immunoterapii, co świadczy o znaczeniu tego nowatorskiego podejścia.
Wśród terapii celowanych wyróżniamy:
- inhibitory kinaz, które potrafią znacząco zmniejszać rozmiar guza w krótkim czasie,
- terapie biologiczne, które są dostosowywane do specyficznych potrzeb pacjentów,
- metody oparte na konkretnych mutacjach genetycznych, co zwiększa szanse na pomyślne wyniki.
Te nowinki sprawiają, że terapia celowana staje się nieodłącznym elementem nowoczesnej onkologii, oferując pacjentom skuteczniejsze i bardziej komfortowe możliwości terapii.
Jak wygląda diagnostyka i kwalifikacja do terapii celowanej?
Diagnostyka i kwalifikacja do terapii celowanej stanowią kluczowe etapy w leczeniu pacjentów z nowotworami. Aby móc skorzystać z tej nowoczesnej formy leczenia, konieczne są testy genetyczne. Dzięki nim lekarze mogą precyzyjnie określić profil molekularny nowotworu, identyfikując specyficzne mutacje w komórkach rakowych. To z kolei pozwala na dobranie najbardziej skutecznej metody terapii.
Cały proces diagnostyczny rozpoczyna się od szczegółowej analizy historii choroby pacjenta, a następnie przeprowadza się różnorodne badania obrazowe oraz laboratoryjne. Kluczowe testy genetyczne, takie jak sekwencjonowanie DNA, umożliwiają wykrycie mutacji w genach powiązanych z nowotworami. Odkrycie unikalnego profilu molekularnego nowotworu otwiera drzwi do zastosowania spersonalizowanej terapii celowanej, która jest dostosowana do indywidualnych potrzeb każdego pacjenta.
Kwalifikacja do terapii celowanej wymaga współpracy specjalistów z różnych dziedzin, takich jak:
- onkolodzy,
- genetycy,
- farmakolodzy.
Po ustaleniu profilu molekularnego i potwierdzeniu mutacji, lekarze podejmują decyzję o rozpoczęciu terapii, która może znacząco wpłynąć na poprawę stanu zdrowia pacjenta.
Warto podkreślić, że proces diagnostyki i kwalifikacji do terapii celowanej jest dynamiczny i może różnić się w zależności od specyfiki nowotworu oraz cech indywidualnych pacjenta.
Jakie są formy podania terapii celowanej?
Terapia celowana oferuje różnorodne metody, co znacznie podnosi komfort pacjentów. Oto najpopularniejsze sposoby jej wdrażania:
- tabletki: to jedna z najchętniej wybieranych opcji, pacjenci mogą je łatwo zażywać w domowym zaciszu, co ułatwia systematyczność leczenia,
- kapsułki: ten sposób również cieszy się dużą popularnością, kapsułki są proste w użyciu i często zapewniają lepsze wchłanianie substancji czynnych,
- zastrzyki: można je podawać zarówno w szpitalach, jak i w domowych warunkach, ta forma leczenia pozwala na szybkie wprowadzenie leku do organizmu, co jest kluczowe w sytuacjach nagłych,
- kroplówki: dzięki nim substancje czynne trafiają bezpośrednio do krwiobiegu, co przekłada się na natychmiastowy efekt, często stosowane w szpitalach, gdzie konieczna jest stała obserwacja stanu pacjenta.
Każda z tych metod terapii celowanej ma swoje unikalne korzyści. Są one indywidualnie dopasowywane do potrzeb pacjentów, co zwiększa efektywność leczenia oraz ogranicza dyskomfort związany z terapią.
Jak wygląda dostępność i koszty terapii celowanej?
Dostępność terapii celowanej w Polsce jest na średnim poziomie. To oznacza, że nie wszystkie nowoczesne leki są łatwo dostępne dla pacjentów. Czas oczekiwania na decyzje refundacyjne z Narodowego Funduszu Zdrowia (NFZ) często bywa długi, co ma wpływ na koszty leczenia. W praktyce pacjenci mogą być zmuszeni do ponoszenia znacznych wydatków na terapie, które nie są objęte refundacją NFZ.
Koszty terapii celowanej mogą sięgać od kilku do kilkunastu tysięcy złotych miesięcznie, w zależności od rodzaju leczenia oraz specyfiki nowotworu. Na przykład terapie takie jak inhibitory CDK4/6 mogą generować wydatki rzędu 5-7 tysięcy złotych na miesiąc. Tak wysokie koszty obciążają budżety pacjentów i mogą prowadzić do rezygnacji z leczenia, co z kolei negatywnie wpływa na rokowania oraz jakość życia.
Jednakże, wraz z wprowadzaniem nowych terapii celowanych, ceny mogą maleć, co daje nadzieję na szerszy dostęp do efektywnych metod leczenia. Istotne jest monitorowanie oraz regularna aktualizacja list refundacyjnych, aby pacjenci mogli korzystać z innowacyjnych terapii w bardziej przystępnych cenach.
Jak monitorować efekty terapii celowanej?
Monitorowanie efektów terapii celowanej jest niezwykle istotne dla oceny skuteczności leczenia oraz wykrywania ewentualnych skutków ubocznych. Aby to zrobić w sposób efektywny, warto zwrócić uwagę na kilka kluczowych elementów:
- Cykliczne badania kontrolne: Pacjenci powinni regularnie uczestniczyć w badaniach, które pozwalają na śledzenie zmian w ich zdrowiu. Badania obrazowe, takie jak tomografia komputerowa (TK) czy rezonans magnetyczny (RM), są nieocenione w ocenie wielkości guzów oraz ich reakcji na podjętą terapię,
- Obserwacja zmian skórnych: W przypadku pewnych terapii, szczególnie w onkologii, kluczowe jest monitorowanie wszelkich zmian skórnych. Skórne efekty uboczne, takie jak wysypki czy zmiany barwnikowe, powinny być regularnie oceniane przez specjalistów,
- Analiza wyników badań laboratoryjnych: Systematyczne badania krwi, w tym kontrola poziomu markerów nowotworowych, są niezbędne do oceny reakcji organizmu na leczenie. Wyniki te mogą wskazywać na poprawę stanu zdrowia pacjenta lub sugerować konieczność wprowadzenia zmian w terapii,
- Prowadzenie dziennika obserwacji: Tworzenie dziennika, w którym pacjent zapisuje swoje objawy, samopoczucie oraz potencjalne skutki uboczne, może znacząco wspomóc lekarzy w personalizacji terapii zgodnie z indywidualnymi potrzebami,
- Konsultacje z zespołem medycznym: Częste spotkania z lekarzem prowadzącym oraz innymi specjalistami, takimi jak onkolodzy, farmakolodzy czy psycholodzy, są nieodzowne. Dzięki nim można na bieżąco dostosowywać leczenie oraz monitorować postępy pacjenta.
Monitorowanie efektów terapii celowanej to proces, który wymaga elastyczności i zaangażowania, a jego celem jest zwiększenie szans na pomyślne wyniki leczenia.
Jak wygląda przyszłość terapii celowanej w onkologii?
Przyszłość terapii celowanej w onkologii zapowiada się niezwykle obiecująco. Dynamiczny rozwój innowacyjnych metod leczenia może znacząco poprawić ich skuteczność. W 2022 roku, podczas 10. edycji Forum Pacjentów Onkologicznych, zwrócono uwagę na ważność nowych kierunków badań, które skupiają się na precyzyjnych strategiach terapeutycznych.
Terapia celowana, która bierze pod uwagę indywidualne cechy genetyczne nowotworów, ma olbrzymi potencjał do wprowadzania kolejnych innowacji. Na przykład, rozwijające się terapie oparte na sztucznej inteligencji mogą przewidywać reakcje pacjentów na konkretne leki, co umożliwia jeszcze bardziej spersonalizowane podejście do leczenia.
Kluczowe w tym procesie będą:
- międzynarodowa współpraca,
- postęp w diagnostyce,
- przyszłe badania kliniczne.
Gdy badania kliniczne będą postępować, nowe terapie mogą zyskać miejsce w rutynowym leczeniu, co zwiększy dostępność nowoczesnych metod.
Innowacje, takie jak terapie CAR-T oraz rozwój immunoterapii, mają szansę stać się standardem w walce z wieloma nowotworami, w tym tymi, które obecnie są szczególnie trudne do wyleczenia.
Przyszłość terapii celowanej w onkologii przynosi ze sobą rosnące możliwości oraz nadzieje dla pacjentów, co czyni tę dziedzinę medycyny niezwykle dynamiczną.
| Terapia celowana | Immunoterapia | Terapie CAR-T | |
|---|---|---|---|
| Skuteczność | Obiecująca | Bardziej skuteczne | Potencjał do innowacji |
| Skutki uboczne | Mniej skutków ubocznych | Mniej skutków ubocznych | Nie wymienione |
| Indywidualizacja | Tak | Tak | Nie wymienione |
| Nowe metody | Innowacyjne metody | Nowe kierunki badań | Nowoczesne metody |
Najczęściej Zadawane Pytania
Jakie są skutki uboczne chemii celowanej?
Skutki uboczne terapii celowanej mogą przybierać różnorodne formy. Wśród najczęściej występujących można wymienić:
- osłabienie,
- uczucie zmęczenia,
- reakcje alergiczne,
- dolegliwości ze strony układu pokarmowego.
W porównaniu do tradycyjnej chemioterapii, terapia celowana zazwyczaj okazuje się łagodniejsza. Należy jednak mieć na uwadze, że każdy organizm reaguje na leczenie inaczej, co sprawia, że doświadczenia pacjentów mogą być bardzo zróżnicowane.
Czy terapia celowana jest skuteczna?
Terapia celowana to innowacyjne podejście, które przynosi pacjentom większe szanse na pozytywne efekty leczenia, ponieważ skupia się na unikalnych właściwościach komórek nowotworowych. W przeciwieństwie do tradycyjnej chemioterapii, ta metoda charakteryzuje się:
- mniejszą ilością skutków ubocznych,
- wyższą skutecznością,
- lepszym dopasowaniem do indywidualnych potrzeb pacjenta.
Dlatego staje się coraz bardziej popularnym wyborem w walce z rakiem.
Jak długo trwa chemioterapia celowana?
Czas trwania chemioterapii celowanej jest różny i zależy od konkretnego rodzaju terapii oraz indywidualnych potrzeb pacjenta. Zazwyczaj leczenie odbywa się w cyklach, które mogą trwać od kilku tygodni do kilku miesięcy. Długość tych cykli w dużej mierze uzależniona jest od tego, jak organizm reaguje na terapię.
Czym się różni immunoterapia od terapii celowanej?
Immunoterapia i terapia celowana to dwie odmienne strategie w walce z nowotworami. Pierwsza z nich wzmacnia układ odpornościowy, co pozwala mu skuteczniej zwalczać komórki rakowe. Z kolei terapia celowana skupia się na konkretnych mutacjach lub białkach, które występują w komórkach nowotworowych. Obie te metody oferują większą precyzję w porównaniu do tradycyjnej chemioterapii.
Jakie są wady terapii celowanej?
Terapia celowana ma swoje minusy. Po pierwsze, jest dość droga, a miesięczne wydatki mogą sięgać kilku, a nawet kilkunastu tysięcy złotych. Warto również pamiętać o ryzyku pojawienia się skutków ubocznych, które mogą obejmować:
- osłabienie organizmu,
- alergiczne reakcje.
Mimo to, często są one mniej uciążliwe w porównaniu do efektów tradycyjnej chemioterapii.
Czy leczenie celowane jest skuteczne?
Leczenie celowane wyróżnia się swoją skutecznością, ponieważ dokładnie koncentruje się na komórkach nowotworowych, co znacząco ogranicza uszkodzenia zdrowych tkanek. W przeciwieństwie do klasycznej chemioterapii, ta metoda oferuje:
- mniejsze ryzyko wystąpienia skutków ubocznych,
- wyższą efektywność działania,
- innowacyjne podejście w terapii nowotworowej.
- www.rp.pl — www.rp.pl/forum-ekonomiczne/art41111891-jacek-jassem-terapia-celowana-to-przelom-w-onkologii
- europacolonpolska.pl — europacolonpolska.pl/terapia-celowana


